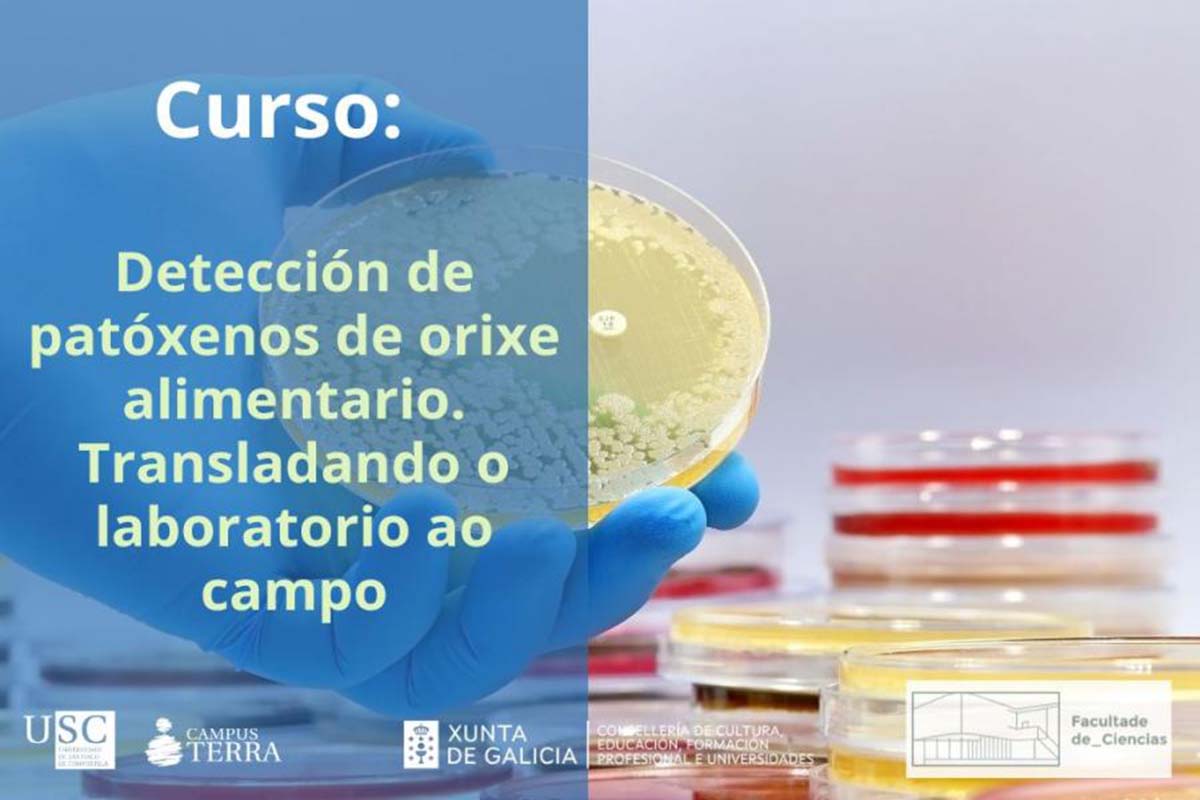

Formación sobre detección de patógenos de origen alimentario en Lugo
La Facultad de Ciencias acoge este curso el 3 de junio y busca facilitar la transferencia al sector productivo de técnicas de microbiología dependientes de cultivo
La Facultad de Ciencias de la Universidad de Santiago de Compostela acoge el 3 de junio la celebración del curso ‘Detección de patógenos de origen alimentario. Trasladando el laboratorio al campo’. La formación pretende facilitar la transferencia al sector productivo de técnicas de microbiología dependientes de cultivo y de biología molecular empleadas de rutina en los laboratorios de seguridad alimentaria, además de abordar aplicaciones prácticas en situación reales. El programa del curso se desarrollará en turno de mañana, de 9:00 a 14:00 horas.
Esta propuesta formativa, coordinada por Alexandre Lamas e impartida por Alejandro Garrido, está incluida en el Plan Formativo 2024 del Campus Terra de la USC. Las personas interesadas en participar en este curso, orientado al estudiantado universitario y también a profesionales y agentes del sector productivo, pueden formalizar ya su inscripción online.
La temática del programa profundizará sobre métodos de microbiología dependiente de cultivo para la detección de patógenos en la cadena alimentaria y también tratará las técnicas moleculares como alternativa más rápida a los métodos de microbiología dependientes de cultivo. Luego, en el curso se explicará de forma teórica y práctica el empleo de técnicas isotérmicas como la amplificación isotérmica mediada por bucle (LAMP, por sus siglas en inglés). Asimismo, también se demostrará de forma práctica como estas técnicas pueden ser aplicadas en la propia industria alimentaria sin necesidad de contar con laboratorios dedicados y con equipación costosa.



